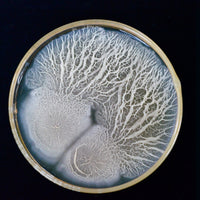

24K Gold Cream Intense


Exclusive Gift
Spend £250+ and indulge in this luxurious set containing deluxe samples of Blanc Peony Face Cream, Blanc Peony Face Serum, and our best-selling Bio Lifting Eye Cream. All beautifully presented in a sleek silver pouch.
The luxurious, ceramide-boosted nourishing cream is powered by advanced botanical technology to target a host of skin concerns, offering moisture, firming benefits and a boost of luminosity.
IMMEDIATELY
97% say skin feels HYDRATED and NOURISHED *
94% agree skin looks SMOOTH and feels SOOTHED *
8 out of 10 say it gives skin a RADIANT GLOW and helps REFINE SKIN TEXTURE *
IN 4 WEEKS
80% say helps visibly IMPROVE overall FACIAL HARMONY *
NASOGENIAN FOLDS and CROW’S FEET WRINKLES APPEAR LESS VISIBLE **
SKIN LOOKS MORE LUMINOUS **
IN 8 WEEKS
SKIN TONE appears MORE EVEN **
SKIN MOISTURE IS ENHANCED (+49%) visibly boosting SKIN ELASTICITY (+31%) **
97% say skin appears less DULL *
*Based on an in-use study of 35 women.
**Based on a clinical trial of 35 women.
Free Of
Free Of
How To Use
How To Use
Ingredients
Ingredients
Aqua/Water/Eau, Glycerin, Rosa Damascena Flower Water, Caprylic/Capric Triglyceride, Pentaerythrityl Tetraethylhexanoate, 2,3-Butanediol, Ethyl Olivate, Lauryl Laurate, Behenyl Alcohol, Butyrospermum Parkii (Shea) Butter, Olea Europaea (Olive) Fruit Oil, Squalane, Cetyl Alcohol, 1,2-Hexanediol, Cetyl Palmitate, Glyceryl Stearates, Jojoba Esters, Stearyl Alcohol, Triheptanoin, Hydroxyacetophenone, Sclerotium Gum, Mica, Helianthus Annuus (Sunflower) Seed Wax, Sodium Stearoyl Glutamate, Bisabolol, Caprylyl Glycol, Ceramide Np, Xanthan Gum, Mannose, Sodium Mannose Phosphate, Tocopherol, Calophyllum Inophyllum (Tamanu) Seed Oil, Rosa Canina Fruit Oil, Yeast Extract, Ophiopogon Japonicus (Ophiopogon) Root Extract, Silica, Diglucosyl Gallic Acid, Sodium Polyglutamate, Citric Acid, Rosa Damascena Flower Oil, Maltodextrin, Sodium Lactate, Tetrasodium Glutamate Diacetate, Vaccinium Macrocarpon (Cranberry) Fruit Extract, Polyglycerin-3, Pelargonium Graveolens (Sweet Scented Geranium) Oil, Acetyl Hexapeptide-8, Gold, Palmitoyl Tripeptide-1, Bacillus Ferment, Palmitoyl Tetrapeptide-7, Citronellol, Geraniol, Linalool, Citral, Sodium Benzoate, Titanium Dioxide (Ci 77891), Copper Powder (Ci 77400)
Please be aware that ingredient lists may change or vary from time to time. To confirm that a Chantecaille product is suitable for your personal use, please consult the list of ingredients that is included on our product packaging.
Reviews
Reviews





Discover 24K Gold Cream Intense
Key Ingredients

Expert Tips

















